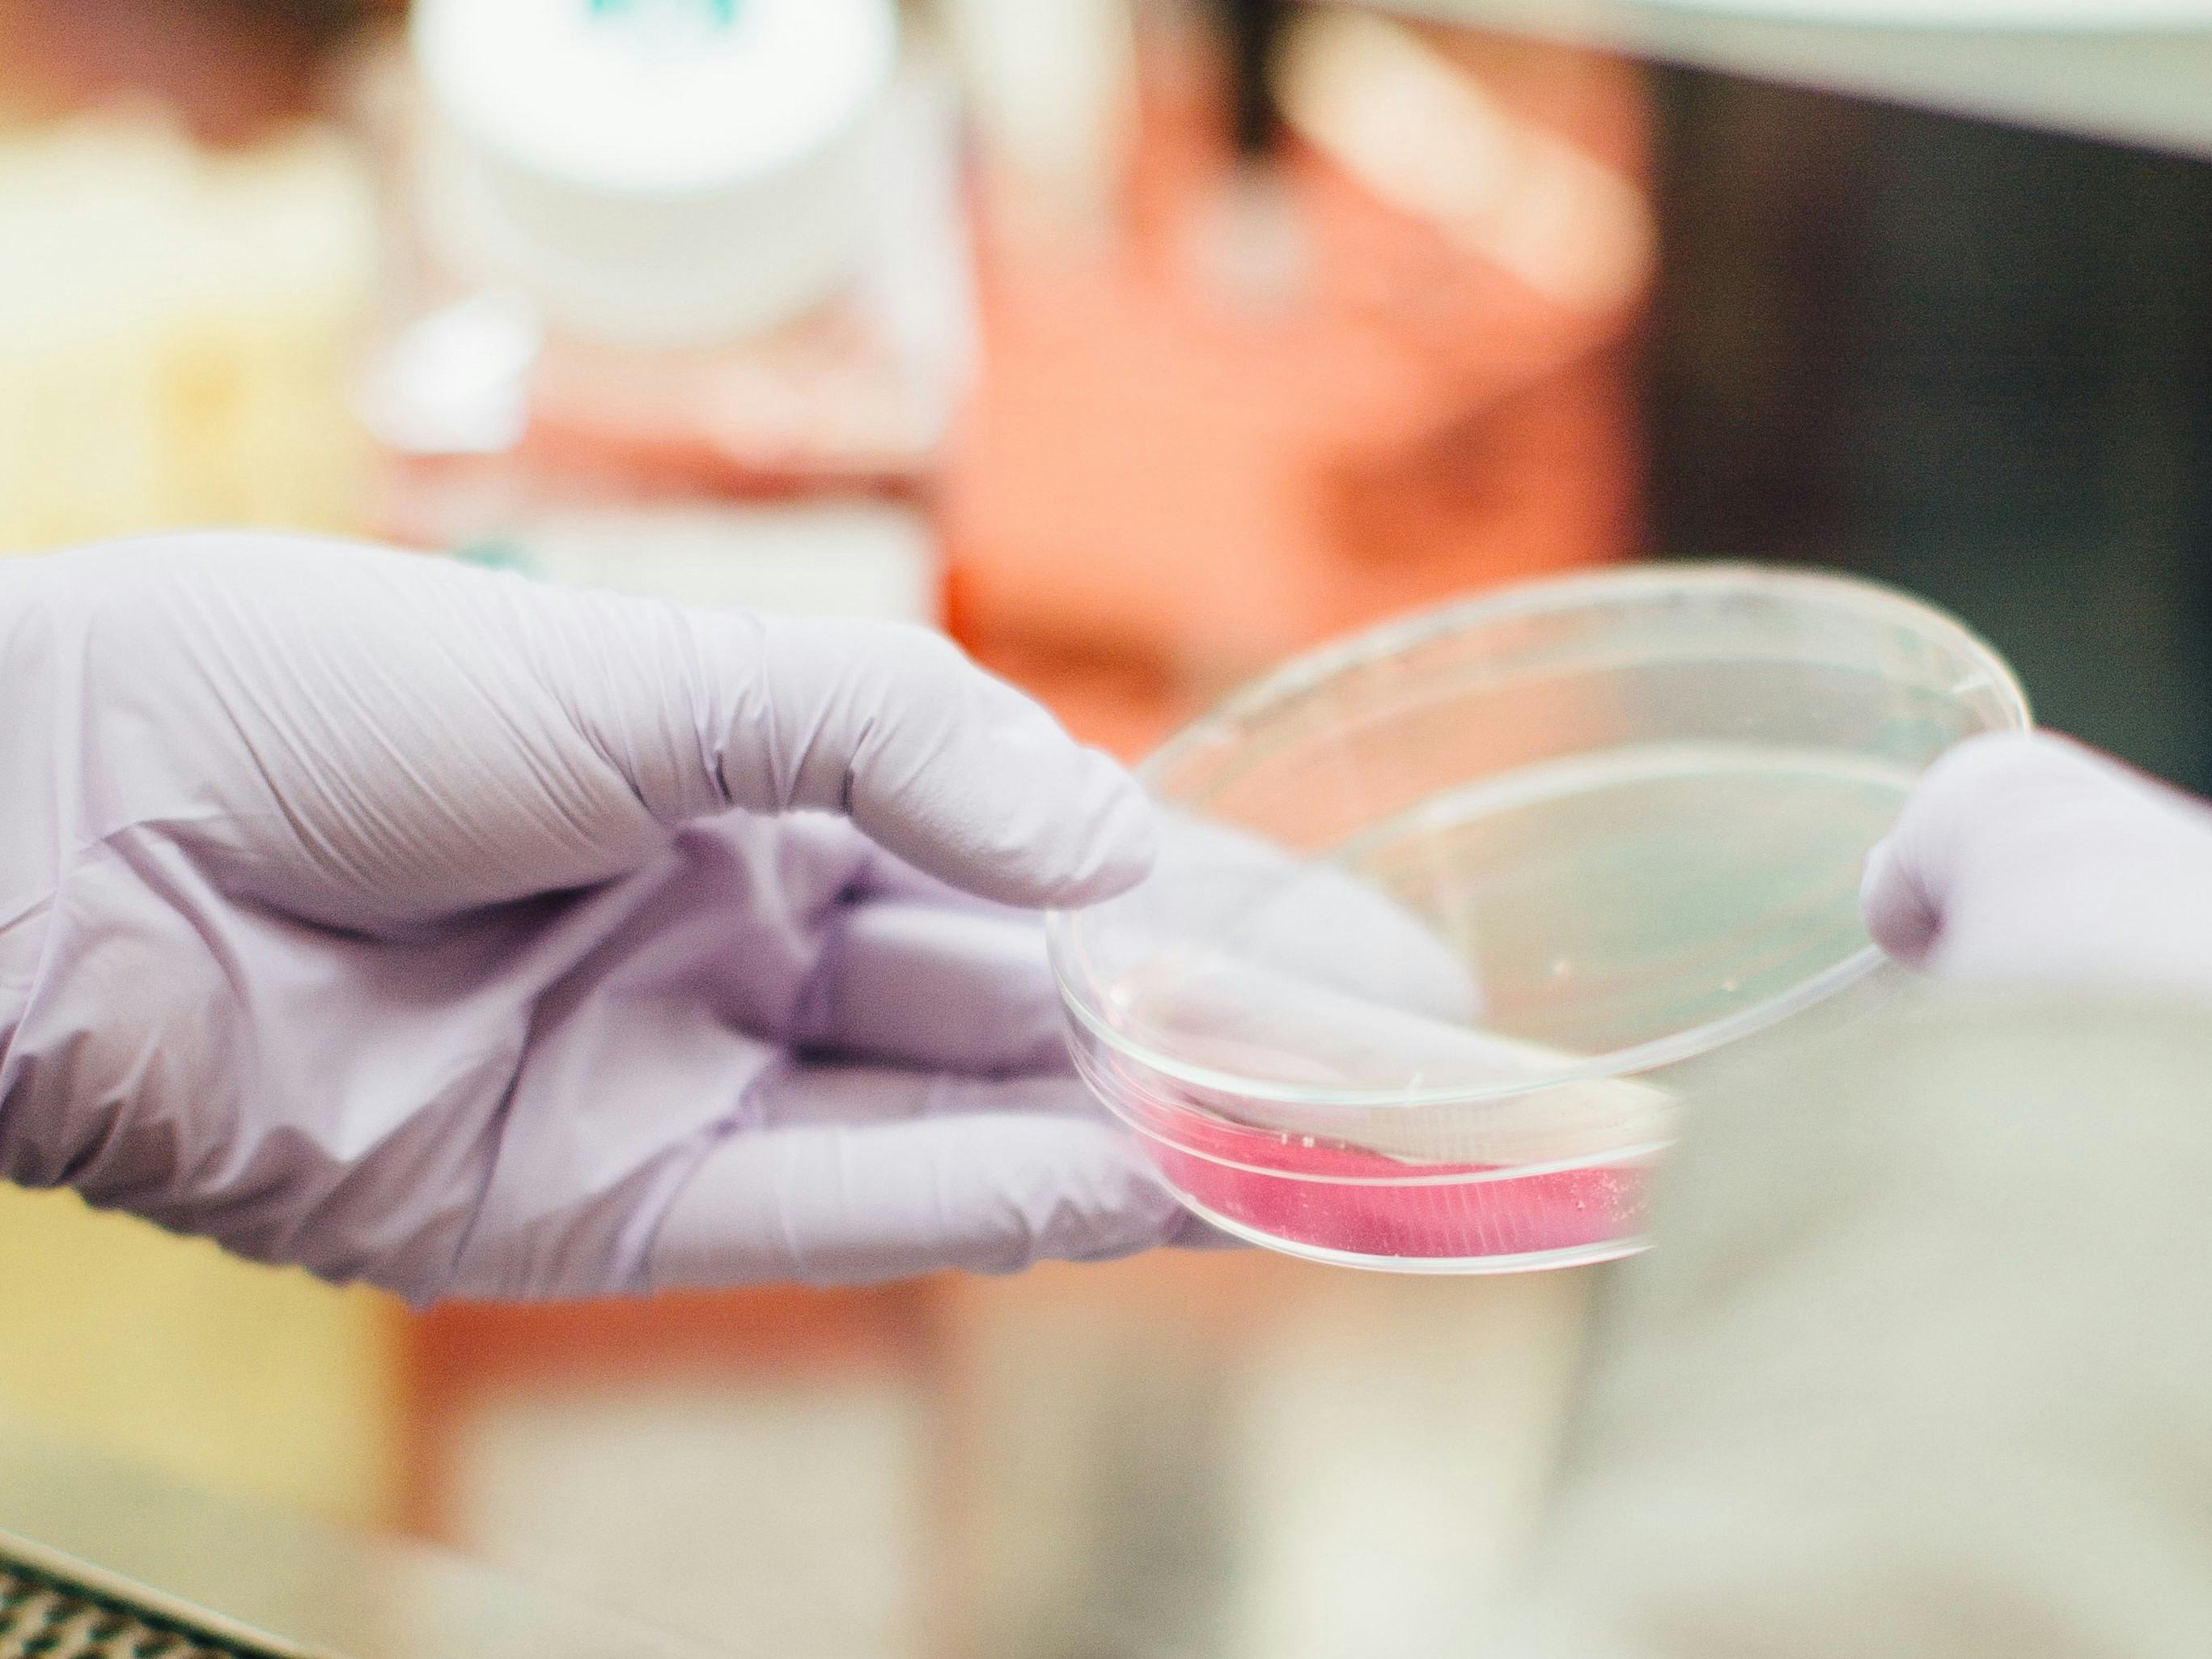

Carmen Groeneveld
Redacteur VMT
Carmen Groeneveld is redacteur bij VMT met als aandachtsgebieden Wetgeving & Toezicht, Ingrediënt & Product, Economie & Bedrijven en startups.

Redacteur VMT
Carmen Groeneveld is redacteur bij VMT met als aandachtsgebieden Wetgeving & Toezicht, Ingrediënt & Product, Economie & Bedrijven en startups.


Unox stapt in koelvers met 5 soepvarianten onder de noemer Puur Soep. Het zijn eenpersoonsporties met 'herkenbare' ingrediënten.

Aleph Farms, een Israëlische kweekvlees start-up, produceerde als eerste een stukje kweekvlees in de ruimte.
Listeria monocytogenes zorgde begin deze maand voor een grote terugroepactie van vleeswaren bij verschillende supermarktketens. De vleeswaren kwamen van vleeswarenproducent Offerman. Haar fabriek in Aalsmeer is per direct gesloten. Naar aanleiding van deze grote terugroepactie brengt VMT de listeria-terugroepacties van de afgelopen drie jaar in kaart. Wat zijn de trends en bevindingen?

Vier op de vijf Nederlanders kiest veelal bewust voor een light of zero drankje, omdat hier minder calorieën in zitten. 54% van de Nederlanders let hier nu meer op dan twee jaar geleden. Millenials maken hierbij de meest bewuste keuzes: 58% let bewust op het aantal calorieën in frisdrank.

De ING deed onderzoek naar plastic verpakkingen in de voedingsindustrie. Naar aanleiding van dit onderzoek formuleerden zij zes oplossingen voor de voedingsindustrie om invulling te kunnen geven aan het plastic vraagstuk.

Fiorruci, een Italiaanse producent, roept de Fiorruci Salame Classico terug vanwege het verkeerd vermelden van de allergenen.

Hessing Supervers, leverancier van vers gesneden groente en fruit, kondigt vandaag de overname van uienverwerker Peter CV aan.

Vleeswarenproducent Offerman haalt tientallen vleeswaren die zijn gesneden en verpakt in zijn fabriek in Aalsmeer, terug uit de winkels. De vleeswaren zijn mogelijk besmet met de listeria bacterie. Jumbo, Bidfood, Aldi, Sligro en Versunie zijn afnemers van deze vleeswaren.

Nederlandse huishoudens verspillen in 2019 minder voedsel dan voorgaande jaren. Zij verspillen per hoofd 7 kilo minder dan in 2016. Dit blijkt uit onderzoek dat is uitgevoerd in opdracht van het Ministerie van Landbouw, Natuur en Voedselkwaliteit (LNV).
 Voor abonnees
Voor abonneesHet Ministerie van Volksgezondheid, Welzijn en Sport (VWS) heeft enkele belangrijke wijzigingen doorgevoerd in het Warenwetbesluit Meel en Brood. VMT zet de tien belangrijkste wijzigingen op een rij.